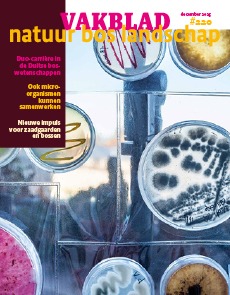

Natte natuur in het klimaatakkoord – win win in het kwadraat
Paul Vertegaal, Wiebe Borren en Barbara Schoute (Natuurmonumenten)
In een eerder nummer van het Vakblad Natuur Bos Landschap werd besproken hoe slim bosbeheer kan bijdragen aan het beter vastleggen van CO2 uit de atmosfeer en daarmee kan bijdragen aan de opgaven voor het in december afgesproken Klimaatakkoord. Naast bos zijn vooral veen- en watergebonden natuurtypen belangrijk in dit opzicht. In dit artikel gaan we daar iets dieper op in.